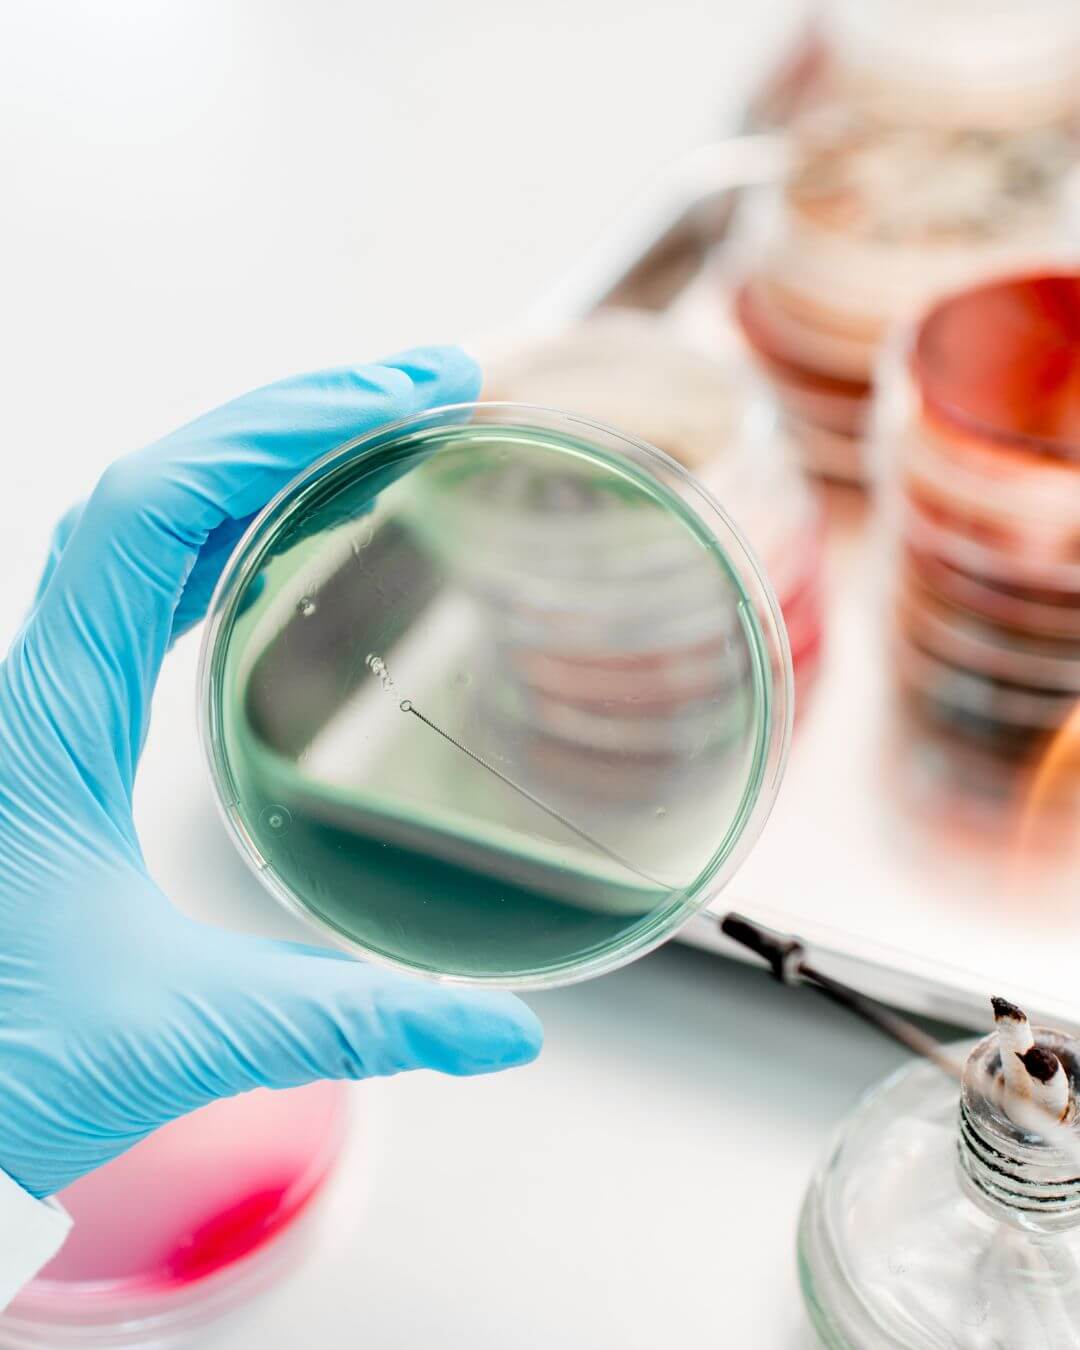
stuhlanalyse buchen

Ein Blick in deinen Darm & Darmflora
kann alles verändern
für mehr Klarheit, Wohlbefinden und Vertrauen in deinen Körper
Dein Darm spricht
Du kannst gerne eine Stuhlanalyse, Darmflora Check bei mir buchen, um ausgewählte Parameter im Labor prüfen zu lassen und herauszufinden, wie es deinem Darm aktuell geht:

aus Interesse


bei ersten Beschwerden
Die Ergebnisse der Stuhlanalyse gehen wir gemeinsam durch.
Ich gebe dir einen verständlichen, ganzheitlichen Überblick, damit du weisst, wo du stehst und wie du deinen Bauch, deine Verdauung sanft unterstützen kannst.

Verstehe deinen Körper, bekämpfe nicht nur die Symptome
Diese Fragen beschäftigen dich im Moment:

Dir fehlt die Klarheit, was in deinem Darm wirklich los ist , du möchtest endlich Fakten statt Vermutungen.

Du möchtest verstehen, warum du trotz gesunder Ernährung oder verschiedener Behandlungen noch Darmbeschwerden hast.

Du willst wissen, ob dein Darmflora im Gleichgewicht ist oder ob stille Entzündungen, Pilze oder Dysbalancen vorhanden sind.

Du fragst dich, ob dein Immunsystem oder deine Hautprobleme etwas mit deinem Darm zu tun haben könnten.

Du wünschst dir Gewissheit, bevor du eine Therapie oder Ernährungsumstellung startest einfach, um zu wissen, wo du stehst.
Nach der Stuhlanalyse:

Du bekommst Klarheit und Sicherheit, weil du endlich weisst, was in deinem Darm passiert, schwarz auf weiss.

Du fühlst dich verstanden und informiert, statt überfordert von Symptomen, die keinen Namen haben.

Du gewinnst Vertrauen in deinen Körper zurück, weil du erkennst, dass hinter deinen Beschwerden konkrete Ursachen stecken.

Du kannst bewusster entscheiden, welche nächsten Schritte, Ernährung, Therapie oder Alltag, für dich sinnvoll sind.

Du spürst Erleichterung, weil du Antworten hast und nicht länger im Dunkeln tappst.
Deine StuhlAnalyse

01.
Auswahl der passenden Analyse
Gemeinsam wählen wir aus, welche Parameter für dich sinnvoll sind z. B. Darmflora, Entzündungsmarker, Pilze, Verdauungsrückstände oder Immunsystem. Ich erkläre dir verständlich, was die einzelnen Werte bedeuten und warum sie relevant sein können.

02.
Probenentnahme zuhause
Du bekommst dein Testkit bequem nach Hause geschickt oder kannst es gleich in meiner Praxis holen/mitnehmen. Mit einer einfachen Anleitung kannst du die Probe selbst entnehmen und sie direkt an das Labor senden schnell, diskret und unkompliziert.
03.
Auswertung deines Befundes
Sobald dein Ergebnis vorliegt, werte ich die Analyse für dich aus. Dabei übersetze ich die Laborwerte in klare, laienverständliche Worte, damit du genau verstehst, was sie bedeuten und was dein Bauch dir sagen will.

04.
Persönliches Feedback & Handout
Du erhältst von mir eine leicht verständliche Auswertung deines Befundes – ergänzt durch ein kleines Handout mit praktischen Tipps, wie du deinen Darm sanft unterstützen kannst. So hast du gleich erste Schritte in der Hand, die du selbst umsetzen kannst.

05.
Möglichkeit zur weiteren Begleitung
Wenn du nach der Auswertung tiefer gehen möchtest, kannst du im Anschluss jederzeit eine ganzheitliche Darmtherapie oder ein Ernährungscoaching bei mir buchen – ganz ohne Druck, nur wenn du bereit bist.

Deine Vorteile mit der Stuhlanalyse
Schon nach kurzer Zeit …

Du gewinnst Klarheit und Verständnis, was in deinem Darm wirklich los ist, endlich Fakten statt Rätselraten.

Du fühlst dich entlastet, weil du weisst, dass deine Beschwerden eine Ursache haben und nicht „nur Einbildung“ sind.

Du bekommst eine verständliche Auswertung, die dir zeigt, wo du ansetzen kannst, ganz ohne Fachchinesisch.
Langfristig …

Du triffst bewusste Entscheidungen, wie du deinen Körper unterstützen möchtest mit Ernährung, Naturheilkunde oder Darmtherapie.

Du entwickelst Vertrauen in deinen Körper, weil du seine Signale besser verstehst.

Du legst die Basis für nachhaltiges Wohlbefinden, indem du nicht nur Symptome beobachtest, sondern Ursachen erkennst.
Deine Extras im „Blick ins Bauchgefühl“ - Stuhlanalyse

eine leicht verständliche Übersicht mit den wichtigsten Erkenntnissen aus deinem Befund, ergänzt durch einfache Alltagstipps für deinen Darm.

Persönliches Feedback
Meine Einschätzung zu deinen Ergebnissen, verständlich erklärt, mit einem Blick auf mögliche Zusammenhänge zwischen Ernährung, Lebensstil und Darmflora.

Kleine Empfehlungen aus der Naturheilkunde, Pflanzenheilkunde oder Achtsamkeit, die deinen Darm auf sanfte Weise unterstützen können.

Nachrichtensupport bei Rückfragen
Du darfst dich nach Erhalt deines Befundes einmal kurz melden, wenn etwas unklar ist oder du einen Punkt genauer verstehen möchtest.





Dein Invest in Klarheit und Verständnis
Für die persönliche Auswertung deiner Stuhlanalyse liegt dein Invest bei 200 CHF *
*(inkl. Handout und individueller Befundbesprechung, exkl. Laborkosten).
Die Laborkosten werden direkt vom Labor in Rechnung gestellt, je nach Umfang der gewählten Parameter. So hast du volle Transparenz und bezahlst nur das, was wirklich getestet wird.


Warum ich die richtige Begleitung für dich bin
Ich bin Nadine, ganzheitliche Darmtherapeutin und Ernährungsberaterin. Mein Weg begann mit eigenen Beschwerden nach einer Magenoperation – daher weiss ich, wie es ist, wenn man einfach verstehen möchte, was im Körper los ist.
Diese Suche nach Klarheit brachte mich zu Darmgesundheit, Darmflora und Laborwerten. Heute verbinde ich moderne Diagnostik mit Naturheilkunde und mache komplexe Befunde verständlich und alltagstauglich.
Was mich auszeichnet:

Fundierte Ausbildungen in Darmtherapie, Ernährungsberatung, Phytotherapie, klassische Massage und Mikronähstoffe.

Eigene Erfahrung mit Magenbypass, Verdauungsproblemen und Nährstoffmangel


So kommst du zu deiner Stuhlanalyse
01.
Formular ausfüllen oder Anfrage senden
Buche einfach die Stuhlanalyse auf meiner Website oder sende mir eine kurze Nachricht mit dem Betreff „Stuhlanalyse“. Ich melde mich bei dir, um kurz zu klären, welche Analyse für dich sinnvoll ist.
02.
Auswahl der passenden Parameter
Gemeinsam besprechen wir, was in deinem Fall getestet werden soll z. B. Darmflora, Entzündungswerte, Verdauungsrückstände oder Immunsystem. So stellst du sicher, dass nur das untersucht wird, was wirklich relevant ist.
03.
Testkit bequem nach Hause erhalten
Das Labor sendet dir das Testkit direkt nach Hause oder du kannst es bei mir in der Praxis abholen / mitnehmen. Du kannst die Probe einfach und hygienisch selbst entnehmen und sie mit dem beigelegten Rücksendeumschlag ans Labor schicken.
04.
Analyse & Auswertung
Sobald dein Befund im Labor ausgewertet ist, erhalte ich die Ergebnisse und werte sie für dich verständlich aus mit Blick auf Zusammenhänge und klare Erklärungen, die du wirklich nachvollziehen kannst.
05.
Persönliche Rückmeldung & Handout
Du bekommst deine Auswertung samt kleinem Handout mit Tipps, wie du deinen Darm sanft unterstützen kannst. Auf Wunsch besprechen wir deine Ergebnisse in einem kurzen persönlichen Gespräch oder schriftlich per E-Mail.
Häufige Fragen zur Stuhlanalyse
Wie läuft die Stuhlanalyse genau ab?

Nach deiner Anfrage besprechen wir gemeinsam, welche Parameter sinnvoll sind. Das Labor sendet dir dann ein Testkit direkt nach Hause oder du holst es bei mir in der Praxis ab. Du entnimmst die Probe selbst und sendest sie ans Labor zurück. Nach der Auswertung bekommst du von mir eine verständliche Analyse deiner Ergebnisse inklusive kleinem Handout mit Tipps.
Muss ich vorher einen Termin in der Praxis haben?

Nein, das ist nicht nötig. Die Stuhlanalyse kann ganz bequem von zuhause aus erfolgen ohne Praxisbesuch. Auf Wunsch können wir deine Ergebnisse später auch persönlich oder online besprechen. Du kannst aber auch sehr gerne bei mir in der Praxis vorbei kommen.
Wie lange dauert es, bis ich mein Ergebnis bekomme?

In der Regel dauert die Auswertung im Labor etwa 10–14 Tage. Sobald dein Befund bei mir eingeht, melde ich mich bei dir und sende dir deine Auswertung mit dem Handout zu.
Was kostet die Stuhlanalyse insgesamt?

Für die Auswertung, Befundbesprechung und dein persönliches Handout beträgt dein Invest 200 CHF (exkl. Laborkosten). Die Laborkosten werden separat direkt vom Labor in Rechnung gestellt, je nach gewählten Parametern.
Welche Werte kann ich analysieren lassen?

Je nach Beschwerdebild oder Interesse können verschiedene Bereiche untersucht werden z. B. Darmflora, Entzündungsmarker, Pilze, Verdauungsrückstände, Gallensäuren oder Immunsystem. Ich erkläre dir genau, welche Parameter für dich sinnvoll sind.
Was, wenn ich „einfach nur neugierig“ bin und keine Beschwerden habe?

Auch das ist möglich. Viele meiner Kund:innen lassen ihren Darm einfach einmal überprüfen, um zu sehen, wie es um ihr Mikrobiom steht als Vorsorge oder aus Interesse an ihrem Körper.
Was passiert nach der Auswertung?

Du bekommst von mir ein kleines Handout mit sanften, individuell passenden Empfehlungen. Wenn du danach tiefer einsteigen möchtest, kannst du dich jederzeit für eine ganzheitliche Darmtherapie oder ein Ernährungscoaching entscheiden, ohne Verpflichtung, ganz in deinem Tempo.

